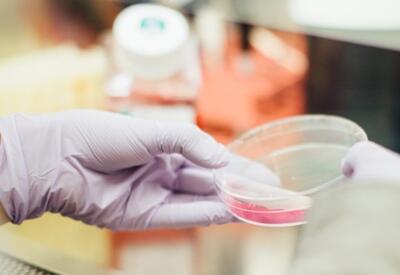

Effective launch and Phase-in-Phase-out (PIPO) planning is vital to minimize the risk of substantial write-offs and waste while ensuring a reliable future product supply. Working closely with the client’s cross-functional team, Triathlon managed the launch and PIPO of an updated product portfolio, achieving successful rollouts in key markets.
Life Science
Triathlon Group serves clients in the Life Science industry, supporting the full range from startups to global companies active within digital health, medical devices, biotech, and pharmaceuticals.
With growing & aging populations, rise of chronic diseases, increased focus on individualized treatments; life science has gained a more important role than ever. At the same time, the industry is transforming with disruptive technologies, creating new opportunities to improve health and how it is delivered.
Cases

Life Science
Launch of Product Portfolio

Life Science
Exploration of New Application Areas
If you venture onto uncharted paths, you may discover promising opportunities. Triathlon supported a leading actor within FoodTech with a market analysis evaluating new potential application areas outside their core focus, enabling accelerated growth opportunities.
If you venture onto uncharted paths, you may discover promising opportunities. Triathlon supported a leading actor within FoodTech with a market analysis evaluating new potential application areas outside their core focus, enabling accelerated growth opportunities.

Life Science
Pre-study to Assess Life Science Center
A client within the academic sector wanted to establish a center specialized in nucleic acid delivery formulation and characterization. Triathlon assisted in exploring the potential and need, finding relevant actors for future collaborations in projects and providing recommendations for next steps.
A client within the academic sector wanted to establish a center specialized in nucleic acid delivery formulation and characterization. Triathlon assisted in exploring the potential and need, finding relevant actors for future collaborations in projects and providing recommendations for next steps.

Life Science
Assessing Precision Medicine Landscape
In the flourishing life science industry, it is important to understand and assess the dynamic landscape. In close collaboration with the client, Triathlon mapped out the precision medicine landscape within the region to form a basis for future investment opportunities.
In the flourishing life science industry, it is important to understand and assess the dynamic landscape. In close collaboration with the client, Triathlon mapped out the precision medicine landscape within the region to form a basis for future investment opportunities.

Life Science
Setup of Project Management Office
Maintaining strong control and clear visibility over your project portfolio is essential for efficient execution. Triathlon supported a client in the MedTech industry to establish and lead a Project Management Office (PMO), delivering enhanced transparency and successful outcomes in critical projects.
Maintaining strong control and clear visibility over your project portfolio is essential for efficient execution. Triathlon supported a client in the MedTech industry to establish and lead a Project Management Office (PMO), delivering enhanced transparency and successful outcomes in critical projects.

Life science
Blood Pump Market Analysis
A team has developed a new type of pump designed to decrease damage to the blood. Triathlon supported the process by providing an analysis of the market for relevant input and possible applications.
A team has developed a new type of pump designed to decrease damage to the blood. Triathlon supported the process by providing an analysis of the market for relevant input and possible applications.

Life science
Identify Entry Points for Novel Innovations
An innovator who developed a novel nanosensor for gas detection sought to explore entry points and market interest for their innovation. Triathlon provided a market analysis to identify appropriate industrial application segments, value chain, and potential for partnerships.
An innovator who developed a novel nanosensor for gas detection sought to explore entry points and market interest for their innovation. Triathlon provided a market analysis to identify appropriate industrial application segments, value chain, and potential for partnerships.

Triathlon Healthtech
AI and Satellite Imagery in Aid
Researchers had developed an AI-powered way to measure sustainable development using satellite imagery to support operations and decision making for the aid sector. Triathlon delivered a market analysis to confirm the solution’s commercial potential and key success factors.
Researchers had developed an AI-powered way to measure sustainable development using satellite imagery to support operations and decision making for the aid sector. Triathlon delivered a market analysis to confirm the solution’s commercial potential and key success factors.
Life Science
Sweden’s Fight Against Infections
An organization with the mission to promote export of Swedish Life science needed support to compile information for a marketing material about Infection control in Sweden. Triathlon gathered information and contributed with storyline, text and data for the marketing material.
An organization with the mission to promote export of Swedish Life science needed support to compile information for a marketing material about Infection control in Sweden. Triathlon gathered information and contributed with storyline, text and data for the marketing material.

Life Science
Health-tech industry analysis
A client with the mission to attract investors to Swedish Life science needed an overview of the Health Tech arena in a Swedish region. Triathlon identified and analyzed 170+ companies and created a presentation material to be used to promote the segment and companies to international investors.
A client with the mission to attract investors to Swedish Life science needed an overview of the Health Tech arena in a Swedish region. Triathlon identified and analyzed 170+ companies and created a presentation material to be used to promote the segment and companies to international investors.

Life science
Investor Pitch for Connected Implant
The ability to clearly convey the value of your innovation to investors is key in the initial stages of a startup. In close collaboration with the client, Triathlon developed an investor pitch outlining an innovative ICT implant and its benefits to patients, thus enabling the next step in the client’s journey.
The ability to clearly convey the value of your innovation to investors is key in the initial stages of a startup. In close collaboration with the client, Triathlon developed an investor pitch outlining an innovative ICT implant and its benefits to patients, thus enabling the next step in the client’s journey.

Novel Medical device for safer sedations
A group of medical and dental researchers had developed a medical device for airway patency during procedural sedation, enabling a safer and more predictable procedure. Triathlon assisted by investigating the market need and requirements, as well as finding relevant actors for future collaborations.
A group of medical and dental researchers had developed a medical device for airway patency during procedural sedation, enabling a safer and more predictable procedure. Triathlon assisted by investigating the market need and requirements, as well as finding relevant actors for future collaborations.

Life science
AI-Powered Platform for Edited Cell Lines
A research team had created an AI-powered search engine for CRISPR-Cas9 edited cell lines with ambition to expand to cell line sharing and delivery. Triathlon assisted by investigating the market need and potential for the platform as well as suggesting suitable business model setup.
A research team had created an AI-powered search engine for CRISPR-Cas9 edited cell lines with ambition to expand to cell line sharing and delivery. Triathlon assisted by investigating the market need and potential for the platform as well as suggesting suitable business model setup.

Life Science
Safeguarding regulatory compliance
A client with the mission to implement the new Medical Device Regulation were under great time pressure, high workload and prioritization challenges. Triathlon developed a way of working with the implementation and coordinated the project to ensure a clear structure and proper priorities.
A client with the mission to implement the new Medical Device Regulation were under great time pressure, high workload and prioritization challenges. Triathlon developed a way of working with the implementation and coordinated the project to ensure a clear structure and proper priorities.

Life science
Medtech Market Plan For Scale-up
A medtech scale-up was in the phase of broad commercialization and scale up. Triathlon supported the client to develop a market plan outlining the strategic efforts to enable future growth based upon a thorough analysis of the current state and growth levers.
A medtech scale-up was in the phase of broad commercialization and scale up. Triathlon supported the client to develop a market plan outlining the strategic efforts to enable future growth based upon a thorough analysis of the current state and growth levers.

Life Science
Healthtech Investor Pitch
An innovative healthtech start-up developing a technology for contactless health measurements had a need to secure additional financing to fund technology development and commercialization. Triathlon supported in developing a communicative investor pitch material.
An innovative healthtech start-up developing a technology for contactless health measurements had a need to secure additional financing to fund technology development and commercialization. Triathlon supported in developing a communicative investor pitch material.

Life science
Partner Analysis for Innovative Materials
A group of researchers developed a way to synthesize innovative materials that can be used to improve the performance of e.g., energy storage solutions. Triathlon assisted in identifying the industry and academic interest and provided recommendations for further development.
A group of researchers developed a way to synthesize innovative materials that can be used to improve the performance of e.g., energy storage solutions. Triathlon assisted in identifying the industry and academic interest and provided recommendations for further development.

Life Science
Exploratory Target Screening
A client within the Life Science Industry needed an initial exploratory screening and analysis of potential acquisitions in a specific industry segment. Triathlon conducted a high-level assessment of the market in question and identified and profiled potential acquisitions.
A client within the Life Science Industry needed an initial exploratory screening and analysis of potential acquisitions in a specific industry segment. Triathlon conducted a high-level assessment of the market in question and identified and profiled potential acquisitions.

Life Science
Explore Need for a New Innovation
A research group found a new method for particle tracking in liquids. Triathlon conducted a market analysis to explore the needs for the new method in different business and research segments, resulting in key input for development and potential collaborations.
A research group found a new method for particle tracking in liquids. Triathlon conducted a market analysis to explore the needs for the new method in different business and research segments, resulting in key input for development and potential collaborations.

Life Science
Pipeline Portfolio Management
Triathlon supported a global medical device client to develop a framework for product pipeline portfolio management yielding a structured analysis and prioritization of new product ideas and product development programs.
Triathlon supported a global medical device client to develop a framework for product pipeline portfolio management yielding a structured analysis and prioritization of new product ideas and product development programs.

Life Science
Medtech Market Planning
A global medical device company has grown rapidly in recent years and needed a market plan to structure future efforts. Triathlon supported the client in the assessment of the current situation and development of a strategic plan with key components in place
A global medical device company has grown rapidly in recent years and needed a market plan to structure future efforts. Triathlon supported the client in the assessment of the current situation and development of a strategic plan with key components in place

Life Science
Market potential & Go-to-market plan
A novel technique to improve development of pharmaceuticals and vaccines had been developed. Triathlon supported the inventors by exploring the commercial potential and interest among potential partners, as well as defining a suitable model for commercialization.
A novel technique to improve development of pharmaceuticals and vaccines had been developed. Triathlon supported the inventors by exploring the commercial potential and interest among potential partners, as well as defining a suitable model for commercialization.

Life Science
Marine biotech partner screening
A novel microalgae cultivation method has been developed for year-round cultivation adapted for the Swedish west coast. Triathlon conducted a comprehensive survey of potential partners and evaluated applications to guide future development for the client.
A novel microalgae cultivation method has been developed for year-round cultivation adapted for the Swedish west coast. Triathlon conducted a comprehensive survey of potential partners and evaluated applications to guide future development for the client.

Life Science
Successful MDR implementation
A global medical device manufacturer had to adapt operations to comply with the new EU MDR. Triathlon established an enterprise-wide action plan and effective follow-up structure to drive implementation.
A global medical device manufacturer had to adapt operations to comply with the new EU MDR. Triathlon established an enterprise-wide action plan and effective follow-up structure to drive implementation.

Life Science
Digital health development & launch
A large global medical device company had set a target to rapidly launch a new digital concept to remain competitive and leverage key industry trends. Triathlon supported with managing and coordinating a cross-functional team resulting in a successful launch that doubled initial sales target.
A large global medical device company had set a target to rapidly launch a new digital concept to remain competitive and leverage key industry trends. Triathlon supported with managing and coordinating a cross-functional team resulting in a successful launch that doubled initial sales target.

Life Science
U.S. expansion plan
To manage FDA requirements and outline the best way to market, Triathlon supported a Swedish MedTech company entering the U.S. with the development of a new business model for the U.S. market. The project resulted in an FDA approval and several contracts secured with major hospitals and clinics.
To manage FDA requirements and outline the best way to market, Triathlon supported a Swedish MedTech company entering the U.S. with the development of a new business model for the U.S. market. The project resulted in an FDA approval and several contracts secured with major hospitals and clinics.

Life Science
Secure project financing
Triathlon supported a startup in need of project funding to verify business concept with a thorough feasibility study through external research and interviews. The work resulted in project funding of 2.5 MEUR for a three-year verification project.
Triathlon supported a startup in need of project funding to verify business concept with a thorough feasibility study through external research and interviews. The work resulted in project funding of 2.5 MEUR for a three-year verification project.

A pharmaceutical client had developed a new innovative product. Triathlon supported the business by analyzing the market attractiveness for their product, resulting in several interested new customers for the client.
A pharmaceutical client had developed a new innovative product. Triathlon supported the business by analyzing the market attractiveness for their product, resulting in several interested new customers for the client.
Featured Insights
Triathlon Group’s AI Study 2026
Triathlon Group’s Generative AI Study 2026 assesses how Sweden’s largest manufacturing companies are moving beyond general purpose GenAI tools such as ChatGPT & Copilot, with emphasis on what enables or prevents collaboration with GenAI startups. The study is based on in-depth interviews with decision makers from manufacturing companies and leaders of prominent GenAI startups, supported by a mapping of the startup ecosystem across five business functions.
Data Sharing Across the Value Chain Is Key for Quantifying Industry Emissions
Most companies focus on reducing emissions they directly control, yet the majority of emissions often occur outside their own operations. As large producing companies seek to quantify and reduce total value chain emissions, upstream actors are pushed to provide emissions data, requiring transparency and collaboration.
FDA Expands Unannounced Foreign Inspections: Are You Prepared for a Knock at the Door?
European MedTech companies are facing a fundamentally new reality. The FDA has formally announced an expansion of unannounced foreign inspections, ending the long-standing advance-notice practice and increasing the overall number of overseas audits. With global oversight intensifying, the question is not whether the FDA will come, but whether your organization can withstand an inspection at any moment.
Triathlon Group’s Industrial Report – Autumn 2025/26
Swedish industrial sentiment has turned more cautious for 2025 as order intake and revenue expectations are revised down versus spring, pressured by weakening demand and trade-policy volatility. Yet the 2026 outlook is clearly brighter: companies anticipate rising order intake and sales, gradual margin recovery, steady headcount, and disciplined, productivity-focused investments, as reflected in Triathlon’s Industrial Index.
Unlocking Business Value from ESG Data
As the first wave of companies (Wave 1) required to report under the CSRD (Corporate Sustainability Reporting Directive) have already published their sustainability statements, the focus is now shifting to the next group (Wave 2), soon approaching their reporting obligation. The need for accurate, traceable, and comparable ESG (Environmental, Social, Governance) data is clear, but ongoing discussions in the EU are creating uncertainty around timing and to what extent the scope of the directive may be reduced. At the same time, this growing data visibility represents far more than a compliance exercise - it is a lever to unlock lasting business value.
2025 AI Study – AI Adoption in the Swedish Manufacturing Industry
Across industries, businesses strive to leverage advancements in AI tomaintain their competitiveness. Developers of AI tools promise transformativegains, including improved operational efficiency, cost reductions, and newrevenue streams. Despite these promises, many companies face challengesin effectively integrating AI into their operations and value propositions.
Five Insights When Developing Software as a Medical Device (SaMD)
Developing Software as a Medical Device (SaMD) is more than a technical challenge, it is a regulated process where clinical safety, software quality, and robust documentation intersect. As the medical device industry increasingly integrates digital capabilities, understanding and applying the right development practices become critical. IEC 62304, the international standard for medical device software, provides the framework, but applying it effectively requires a hands-on mindset. Here are five key insights that every development team should consider.
Triathlon Group’s Industrial Report – Spring 2025/26
Triathlon Group’s Spring 2025/26 Industrial Report notes a good start to 2025, following a strong Q1. However, rising uncertainty in Q2 has made the outlook for the rest of the year more cautious. Still, expectations for 2026 remain positive, with forecasts pointing to stabilization and improved margins.
Mastering Inventory Management
Mastering inventory management is a central part of today's supply chains. It affects not only cost levels but also on-time delivery, customer satisfaction, and how well a company handles fluctuations in demand and supply. No longer a background function, inventory management has become a strategic lever for long-term, well-informed decisions.
The Strategic Impact of Data-Driven Decision-Making
In today’s fast-moving economy, decision-making based solely on intuition is uncertain. Organizations that embed data into decision-making gain the clarity needed to navigate risks, seize opportunities, and drive sustained growth. Treating data as a strategic asset doesn’t just improve efficiency, it redefines how businesses compete and succeed.
Strategy - The Key to Unlocking Full AI Potential
Most executives believe that AI is a key enabler to reach growth targets, yet many companies struggle to successfully adopt AI. What differentiates companies who succeed with their AI transformations from those who do not? Triathlon Data & Analytics is surveying manufacturing companies to investigate what obstacles they encounter, as well as how they are overcome.
Triathlon Group’s Industrial Report 2024/25
Triathlon Group's annual Industrial Report shows that the Swedish manufacturing industry faces significant challenges during 2024. However, many companies are optimistic about a recovery and better market conditions in 2025.
Ensure a Truly Efficient BI Improvement Process
Implementing a BI solution is an accomplishment, concurrently only the beginning. To fully grasp the benefits, BI maintenance and continuous improvements are...
Life science trends outlook
5 trends to watch
The life sciences sector is evolving rapidly, driven by technological advancements, market dynamics and the need for effective, efficient and patient-centric solutions. The post-pandemic years have been shaped by uncertainty and instability, combined with sharper regulatory requirements raising the barrier to market. As we look ahead, several key trends are poised to shape the industry’s future.
Triathlon Group’s Industrial Report 2024/25
Triathlon Group's industrial report (Verkstadsrapporten) highlights a challenging year for Swedish manufacturing companies, with expected decline in top-line growth, order intake, and workforce. For 2025, the companies show a cautious optimism for market recovery.
Challenges & Opportunities in AI-based MedTech
Artificial intelligence (AI) has emerged as a catalyst for innovation in the HealthTech domain, with the promise to enable faster, smarter and more effective care to people across the globe.
Safeguarding Against Escalating Digital Threats
Cybersecurity involves measures aimed at preventing and safeguarding your digital infrastructure from cyberattacks. Ransomware, an attack particularly successful in disclosing confidential data, is a threat to companies of all sizes across all industries.
Increased Sustainability Requirements Demand Automated Processes
The requirements for Sustainability reporting have increased significantly during recent years, challenging companies’ processes for reporting. Implementing an automated reporting platform can significantly limit dependency on individuals, streamline manual work and reduce the risk of errors.
Data engineering to unlock the potential of BI
Business intelligence (BI) supports organizations to extract valuable insights from their unstructured and structured data to facilitate strategic decisions. However, unlocking this potential requires complex data to be managed through data engineering, including data ingestion, storage and processing, before it can be transformed into tangible values...
Triathlon Group’s Industrial Report 2023/24
Triathlon Group's annual industry report (Verkstadsrapporten) shows a strong top-line growth during 2022 for Swedish and West Swedish manufacturing companies. Despite growing top-line, West Swedish companies express concerns regarding the possibility of passing on increased cost, which is expected to lead to reduced profitability...
Is the Semiconductor Crisis Over?
The world has, in recent years, become acutely aware of the elusive group of components referred to as semiconductors. Their pervasive influence touches every facet of the modern business landscape, from automotive giants to consumer electronics titans. However, what was once an unassailable cornerstone of innovation has now become a fragile keystone in the worldwide economy. These components are not only the brains behind our gadgets but are...
Nucleic Acid Therapies – A Medicinal Revolution
Nucleic acid therapeutics are changing healthcare by offering transformative potential to treat diseases by targeting their genetic blueprints. Ins...
Emerging Transportation Management Systems
Emerging and disruptive technologies such as AI, Cloud Computing, Big Data Analytics, and Autonomous Vehicles have unlocked untapped potential for Tra...
Democratizing Healthcare by Machine Learning
Machine learning is revolutionizing businesses, through valuable insights, predicted outcomes, and facilitated decision-making. In healthcare, the models efficiently analyze patient data, identify anomalies and offload staff. But besides a reliable algorithm...
Succeeding in IT and Business Carve-Outs
Executing an IT separation within a business carve-out can be a daunting task for leadership teams. However, by considering the following points, the transformation can be executed with greater efficiency and clarity...
Co-opetition – Collaborate With Competitors to Get Ahead
Originating from game theory, co-opetition describes how competitors can cooperate to get ahead, or reach a common goal, by working together. Despite its benefits in the prevailing business climate, competitors are – as you might know – often hesitant to collaborate, and as a result, they miss out on favorable opportunities...
Assessing Environmental Impact With LCA
Organizations meet increased pressure to disclose their environmental impact. A Life Cycle Assessment (LCA) is a standardized methodology that quantifies this impact, providing data for organizations to address the increased demand.
Increased need to quantify environmental impact
Organizations are under increasing pressure to be transparent about their environmental performance. Firstly, the legal reporting requirements are becoming ever stricter, which is illustrated by...
OKR – An Effective Tool to Drive Goal Achievement
Developed by Intel’s CEO Andy Grove back in the 1970’s, the goal and management method Objectives and Key Results (OKR) has since become the de facto methodology for many tech giants like Google, Amazon and Spotify and is spreading like wildfire across successful startups. The method enables companies achieve their goals by focusing on what is most important – at any given time...
Supply Chain Resilience in a Market Downturn
The robust growth since the last global recession in 2008/2009 has reached its climax. We are now forced to face a stark new reality as a recession ominously looms in the not-so-distant future. It is hard to deny that the last two years have been challenging from a supply chain perspective, many were caught off-guard and supply chain inefficiencies were mercilessly punished...
Combining Data Privacy & Machine Learning
The development of computing capabilities during the last decades has enabled organizations to gather and process large amount of data using advanced mac...
Gain Efficiencies by Product Variant Strategies
When companies extend offerings through product variants, they will face increasing costs and related challenges as the portfolio grows in complexity. Concurrently, variants generate deep customer value and justify higher price points, where mitigation strategies will enable improved lead times and profits gains...
Triathlon Group’s Industrial Report 2022/23
Triathlon Group’s annual Industrial Report (Verkstadsrapporten) shows that the Western Sweden’s manufacturing industry have recovered after the pandemic. However, high inflation, higher interest rates, continued material shortages and increasing energy prices result in that companies are uncertain about the future demand...
The M&A Year 2021 in Review and 2022 Outlook
M&A activity in Europe surged in 2021 with more capital spent on acquisitions than any of the previous seven years. After a relatively poor 2020, transaction volumes bounced back to pre-pandemic levels and more. Has the M&A market scaled new heights in Europe?
Study Shows 3 Enablers for Sustainability Leadership
The global sustainability transformation is rapidly evolving. To enable a successful transformation and ultimately become a sustainability leader, fulfilling organizational prerequisites is key. Based on a study* of companies at the sustainability forefront and interviews with sustainability executives, Triathlon Group has identified three organizational enablers for success...
A Paradigm Shift Within Digital Services?
Have you ever read the comments field on an article posted on social media? Then you have probably encountered both hatred and the spread of disinformation. Wit...
Building a Culture of Innovation
Innovation is a key recipe for success, yet most organizations still struggle to generate and execute enough new ideas to the desired level of novelty. The...
Mandatory Human Rights and Environmental Due Diligence
The long-awaited proposal for an EU Directive on mandatory human rights and environmental due diligence has finally been released, following the increasing global momentum towards socially responsible and sustainable business. A topic that in times like these is ever more relevant.
Navigating the regulatory space for MedTech AI
Artificial Intelligence (AI) holds unprecedented potential to transform how healthcare is delivered and will be vital to enable qualitative and cost-effective care in the future. However, the regulatory landscape for the intersection between healthcare and AI creates new challenges for innovators. Challenges that need to be successfully managed to launch new AI-medtech.
What is your contribution to Agenda 2030?
United Nations’ 17 Sustainability Development Goals (SDG) show the direction on how to make an impact on the world’s most urgent societal challenges. These goals aim to mobilize efforts and they call for action to organizations around the globe to use innovation and creativity to combat these challenges.
Triathlon Group’s Industrial Report 2021/22
Triathlon Group’s annual Industrial Report (Verkstadsrapporten) shows that the Western Sweden’s manufacturing industry was initially hit hard by the COVID-19 pandemic in 2020, but recovery has been rapid and forecasts for the future are positive. However, uncertainties exist on how the cost development of raw materials and transports will progress, which is indicated in this year’s report.
Infection Control – mapping of strongholds in West Sweden
Following the increased concerns surrounding healthcare-associated infections, Infection prevention and control has become an increasingly more important, and regulated, top priority. A priority that has become even more accentuated during the ongoing coronavirus outbreak.
Get Topline Impact from Value-Driven Sales
Project sales between businesses are complex and to succeed with a high hit-rate, the sales process needs to turn from a traditional selling with inside-out to an outside-in perspective. By identifying the unique buying points for the customer, new ways of selling are derived that can impact topline results.
Study on realization of ERP benefits
Expectations on a new ERP-system are often high. However, once the system goes live, studies show that most businesses experience unachieved realizations of their expected benefits.
The M&A Year 2020 in Review
Heading into 2020, global M&A activity was declining, with both a deal value and deal count falling in 2019 compared to the all time high levels of previous years.
Eliminate the Skill Gap for Value-Based Sales
A sales force which has the skills to identify and sell value is necessary to meet the challenges with value-based sales.